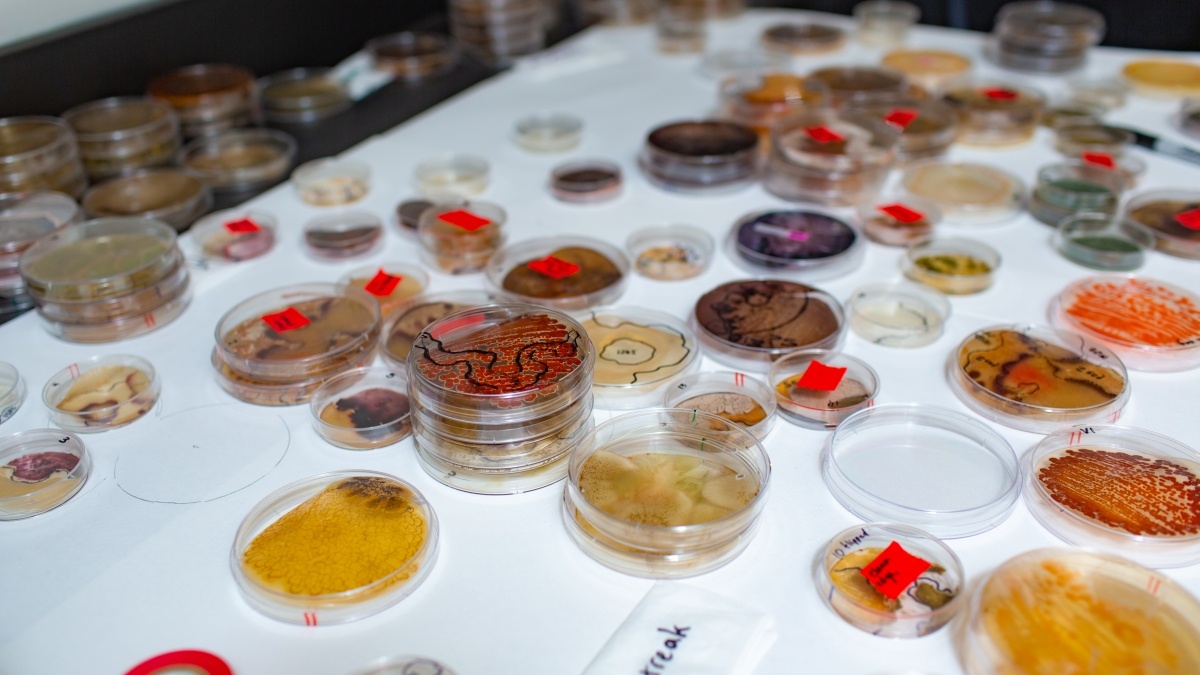
Lab table covered in petri dish samples.

Overview
What You'll Study
Molecular and biochemical principles and tools that help us understand biological systems
Faculty
Undergraduate-focused faculty mentors
BCMB faculty research and teaching expertise span broad disciplinary levels of biology and chemistry, including bioorganic chemistry, biochemistry, virology, microbial/cell/organismal physiology, cell biology and neuroscience.
Student Opportunities
Undergraduate student-centered multidisciplinary training and research opportunities
Scholarships
McNair Scholars Program
The Ronald E. McNair Post-Baccalaureate Achievement Program (the McNair Scholars Program) prepares well-qualified undergraduate students for success in doctoral studies through involvement in research and other scholarly activities.
Dr. J. Wilfrid Hahn Scholarship
This scholarship award is given in memory of Dr. Hahn to eligible BCMB majors in excellent academic standing.
Honors Programs
BCMB majors can pursue honors research with faculty mentors in Chemistry, Biology, or other programs, culminating in the preparation and presentation of a written thesis.
Research Opportunities
BCMB students can join faculty research laboratories and pursue projects and experimental work.
Maeder Lab
Research in the Maeder Lab centers on characterizing a key mechanism in gene expression, pre-messenger RNA splicing. Splicing precisely removes non-protein coding sequences from RNA prior to translation into proteins. The mechanism involves large-scale rearrangements of protein-RNA complexes, which must be regulated to ensure both splicing timing and accuracy. Our current work focuses on identifying the mechanisms by which several essential splicing proteins regulate spliceosome assembly and activation. We use a variety of biochemical, molecular biological, and genetics techniques to dissect the importance of protein-nucleic acid and protein-protein interactions in the spliceosome.
Hunsicker-Wang Lab
The Hunsicker-Wang lab explores the relationship between protein structure and function. Researchers study metalloproteins from a unique bacterium, Thermus thermophilus. These proteins have high stability and make them amenable for structural studies using X-ray crystallography. The proteins that are studied are involved directly or indirectly in the respiration process. The lab uses a combination of mutagenesis, chemical modification, and spectroscopic and structural tools to study these proteins.
Study Abroad
In consultation with their academic advisers and the Study Abroad Office, BCMB majors can plan study abroad experiences as part of their degree program.
Facilities
Center for the Sciences and Innovation
Multidisciplinary undergraduate-centered research opportunities exist in Trinity’s Center for the Sciences and Innovation. The facility features 280,000 square feet of cutting-edge lab and classroom spaces, where students can develop and work on projects, and learn techniques and instrumentation use.
Student Organizations
Students can become members of the American Society for Biochemistry and Molecular Biology (ASBMB). ASBMB members can apply for travel awards to present their research at national conferences.
Student Awards
Outstanding BCMB Student
This award recognizes a single graduating BCMB major for academic and research excellence in the BCMB program.
Mach Research Fellowship
Endowed by Steven Mach (Trinity University Class of 1992), the Mach Fellowships provide funding to rising seniors in STEM programs to support senior year research projects.
Events
BCMB students can explore their disciplinary interests through attendance at seminar events hosted by Biology, Chemistry, Physics and other departments.
When You Graduate
Prepared to find solutions
Whether they continue their education or enter the professional world, graduates are well-versed in the disciplines of chemistry and biology and are equipped to approach problems and offer solutions at the intersections of chemistry and life sciences.
Careers
BCMB majors pursue graduate work in biochemical and life sciences. Many graduates attend medical school or postbaccalaureate study in other allied health professions, or enter careers in biotechnology, biomedical sciences, pharmaceutical sales, industry and teaching.
Take the next step
Have more questions or want more information? Learn more about becoming a Tiger, and how you can accelerate what’s next for your education.